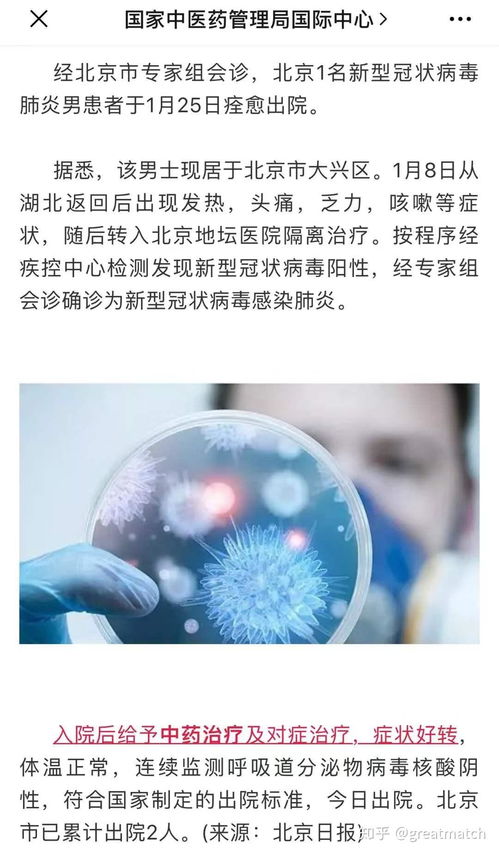
2019年新型冠状病毒，深入了解与应对策略

亲爱的读者们,今天我们将一起探讨一个全球性的健康话题——2019年新型冠状病毒(COVID-19),自2019年底首次在中国武汉出现以来,这种病毒已经迅速传播至全球各地,对公共卫生、经济和社会生活产生了深远影响,本文将为您提供关于这种病毒的详细信息,包括它的起源、传播方式、预防措施以及疫苗接种的重要性。
病毒的起源
2019年新型冠状病毒(SARS-CoV-2)是一种冠状病毒,与严重急性呼吸综合征冠状病毒(SARS-CoV)和中东呼吸综合征冠状病毒(MERS-CoV)同属一个家族,据研究,SARS-CoV-2很可能起源于蝙蝠,并通过中间宿主(可能是穿山甲)传播给人类,病毒首次在武汉的海鲜市场被发现,随后迅速传播。
病毒的传播方式
SARS-CoV-2主要通过飞沫传播,当感染者咳嗽、打喷嚏或说话时,病毒会通过飞沫进入空气,然后被其他人吸入,病毒也可以通过接触传播,即当人们触摸被病毒污染的物体或表面,然后触摸自己的口、鼻或眼睛时,病毒就可能进入人体,研究表明,病毒在空气中和物体表面上的存活时间相对较长,这增加了传播的风险。
预防措施
为了减少感染风险,世界卫生组织(WHO)和各国卫生部门推荐了一系列预防措施:
勤洗手:使用肥皂和水,或含有至少60%醇的洗手液,至少洗手20秒。
保持社交距离:与他人保持至少1米(3英尺)的距离,尤其是在公共场合。

佩戴口罩:在无法保持社交距离的情况下,佩戴口罩可以减少飞沫传播。
避免拥挤的地方:尽量减少前往人群密集的地方。
咳嗽和打喷嚏时的礼仪:使用纸巾捂住口鼻,或将手肘弯曲捂住,避免用手直接接触。
疫苗接种的重要性
疫苗是控制疫情和恢复正常生活的关键,全球范围内,科学家们迅速行动,开发了多种COVID-19疫苗,这些疫苗通过激发人体免疫系统产生对病毒的保护性反应,从而减少感染和重症的风险,以下是疫苗接种的一些关键点:
群体免疫:当足够比例的人口接种疫苗后,病毒传播将受到限制,这被称为群体免疫。
减少重症和死亡:疫苗可以显著降低感染后发展为重症和死亡的风险。
保护弱势群体:老年人和有基础疾病的人群尤其需要疫苗的保护。
疫苗的种类和选择
市面上有多种COVID-19疫苗,包括mRNA疫苗(如辉瑞-BioNTech和Moderna)、病毒载体疫苗(如阿斯利康和强生)以及灭活病毒疫苗(如科兴和国药),每种疫苗都有其独特的优势和特点,选择疫苗时应考虑个人健康状况、疫苗的可获得性以及医生的建议。

疫苗接种后的注意事项
即使接种了疫苗,也应继续遵循预防措施,因为疫苗可能无法提供100%的保护,疫苗对新出现的病毒变种的保护效果可能会有所降低,因此持续监测和更新疫苗是必要的。
未来展望
随着疫苗接种率的提高和治疗方法的改进,我们有望逐步控制疫情,这也要求全球各国加强合作,共享资源和信息,以应对未来的公共卫生挑战。
2019年新型冠状病毒是一个全球性的挑战,它考验了我们的医疗系统、社会结构和个人行为,通过了解病毒的传播方式、采取有效的预防措施以及积极接种疫苗,我们可以保护自己和他人,共同战胜这一挑战,希望本文能为您提供有价值的信息,并鼓励您继续探索更多关于COVID-19的相关知识,让我们携手合作,为一个更健康、更安全的未来而努力。








